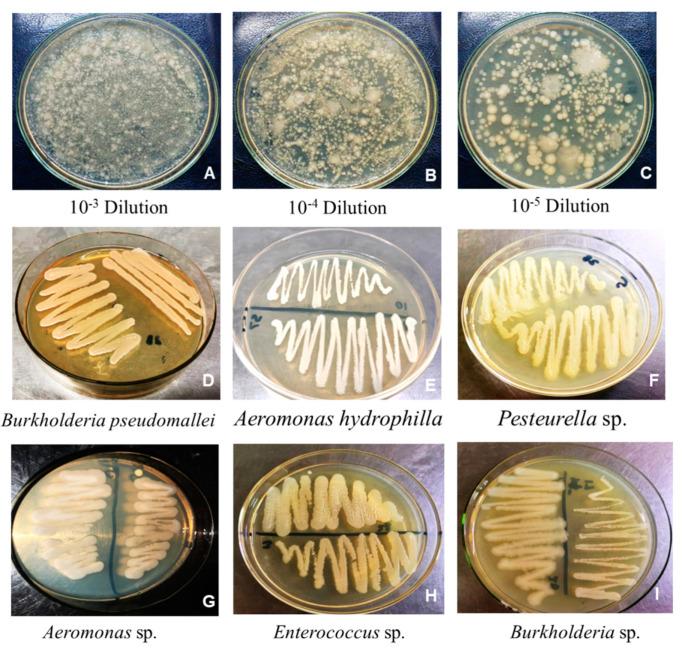
https://cdn.ncbi.nlm.nih.gov/pmc/blobs/af0b/11510893/b385998064a9/plants-13-02875-g001.jpg

一种基于小说的纳米肥料促进小麦(L.)幼苗生长和活力。
A Novel -Based Nanofertilizer Promotes Seedling Growth and Vigor in Wheat ( L.).
作者信息
Batool Salma, Safdar Maryam, Naseem Saira, Sami Abdul, Saleem Rahman Shah Zaib, Larrainzar Estíbaliz, Shahid Izzah
机构信息
Department of Basic and Applied Chemistry, Faculty of Science and Technology, University of Central Punjab, 1-Khayaban-e-Jinnah Road, Johar Town, Lahore 54782, Pakistan.
Department of Biotechnology, Faculty of Science and Technology, University of Central Punjab, 1-Khayaban-e-Jinnah Road, Johar Town, Lahore 54782, Pakistan.
出版信息
Plants (Basel). 2024 Oct 14;13(20):2875. doi: 10.3390/plants13202875.
Excessive use of chemical fertilizers poses significant environmental and health concerns. Microbial-based biofertilizers are increasingly being promoted as safe alternatives. However, they have limitations such as gaining farmers' trust, the need for technical expertise, and the variable performance of microbes in the field. The development of nanobiofertilizers as agro-stimulants and agro-protective agents for climate-smart and sustainable agriculture could overcome these limitations. In the present study, auxin-producing sp. SR9, based on its plant growth-promoting traits, was selected for the microbe-assisted synthesis of silver nanoparticles (AgNPs). These microbial-nanoparticles SR9AgNPs were characterized using UV/Vis spectrophotometry, scanning electron microscopy, and a size analyzer. To test the efficacy of SR9AgNPs compared to treatment with the SR9 isolate alone, the germination rates of cucumber (), tomato (), and wheat ( L.) seeds were analyzed. The data revealed that seeds simultaneously treated with SR9AgNPs and SR9 showed better germination rates than untreated control plants. In the case of vigor, wheat showed the most positive response to the nanoparticle treatment, with a higher vigor index than the other crops analyzed. The toxicity assessment of SR9AgNPs demonstrated no apparent toxicity at a concentration of 100 ppm, resulting in the highest germination and biomass gain in wheat seedlings. This work represents the first step in the characterization of microbial-assisted SR9AgNPs and encourages future studies to extend these conclusions to other relevant crops under field conditions.
过度使用化肥对环境和健康构成了重大问题。基于微生物的生物肥料作为安全替代品正越来越多地得到推广。然而,它们存在一些局限性,比如难以获得农民的信任、需要技术专长以及微生物在田间的表现不稳定。纳米生物肥料作为气候智能型和可持续农业的农业刺激剂和农业保护剂的开发可以克服这些局限性。在本研究中,基于其促进植物生长的特性,选择了产生长素的sp. SR9用于微生物辅助合成银纳米颗粒(AgNPs)。使用紫外/可见分光光度法、扫描电子显微镜和粒度分析仪对这些微生物纳米颗粒SR9AgNPs进行了表征。为了测试SR9AgNPs与单独使用SR9菌株处理相比的效果,分析了黄瓜()、番茄()和小麦(L.)种子的发芽率。数据显示,同时用SR9AgNPs和SR9处理的种子比未处理的对照植株表现出更好的发芽率。在活力方面,小麦对纳米颗粒处理的反应最为积极,其活力指数高于所分析的其他作物。SR9AgNPs的毒性评估表明,在浓度为100 ppm时没有明显毒性,这使得小麦幼苗的发芽率和生物量增加最高。这项工作代表了微生物辅助的SR9AgNPs表征的第一步,并鼓励未来的研究将这些结论扩展到田间条件下的其他相关作物。